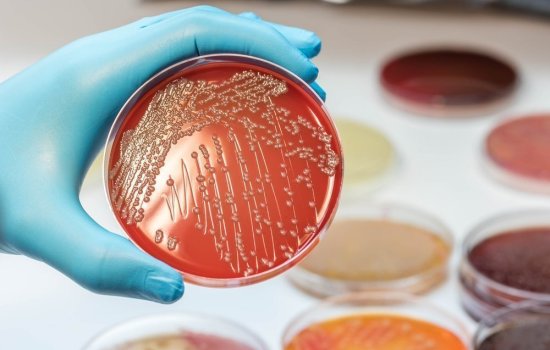

Колибактин – токсин, вырабатываемый кишечной палочкой, который может вызывать рак толстой кишки. Результаты, описанные в журнале Science,приведут к разработке теста, который эффективно оценит риск развития рака толстой кишки.
Как кишечная палочка влияет на риск рака?
Большинство видов кишечной палочки, которые населяют кишечник человека, безвредны. Некоторые штаммы даже полезны, поскольку производят витамин К. Другие, однако, могут вызвать смертельные инфекции.
В 2006 году было обнаружено, что некоторые кишечные палочки способствуют развитию рака толстой кишки за счет высвобождения токсинов – колибактинов.
Кишечная палочка с геном колибактина была обнаружена у пациентов с раком толстой кишки. Она также может быть причиной того, что у людей с язвенным колитом чаще развивается рак толстой кишки.
Анализ, который обнаруживает колибактин в образцах стула, может представлять интерес для оценки риска рака толстой кишки. Однако токсин производится только в небольших количествах. Молекула также нестабильна, поэтому шансы на прямое обнаружение рака невелики.
Новый тест поможет быстро выявлять рак толстой кишки
Команда, возглавляемая учеными из Гарвардского университета, сейчас разработала косвенный тест. Он обнаруживает различные последствия действия колибактина.
Токсин, вероятно, не является единственным канцерогенным веществом, продуцируемым кишечными бактериями. Однако может потенциально использоваться для общей оценки риска.
Исследователи еще не так далеко продвинулись в понимании вреда бактерий. Тем не менее они смогли точно определить, как колибактин связывается с ДНК. Изменения в геноме специалисты хотят использовать для оценки риска рака.
Воспаление также вызывает рак толстой кишки
Язвенный колит, и, возможно, болезнь Крона, связаны с увеличением частоты рака, ограниченного толстой кишкой. Эксперименты на животных в настоящее время предполагают, что кишечные бактерии участвуют в развитии опухолей.
Американские ученые экспериментируют с мышами, у которых развивается воспаление кишечника из-за генной мутации. Пока животные не содержат микробов, они остаются здоровыми.
Согласно исследованиям, подопытные мыши с неповрежденной флорой имеют тяжелое воспаление кишечника, если к ним подселяют больных сородичей. Также у большинства развивается рак толстой кишки.
Тот факт, что бактерии в принципе могут способствовать развитию рака, известен. Наиболее ярким примером является Helicobacterpylori, который сегодня считается основной причиной рака желудка. Но почему у здоровых мышей и людей рак кишечника редко развивается, а риск язвенного колита значительно повышается? Обследование кишечной флоры больных животных может дать объяснение этому.
Как предотвратить рак толстой кишки?
Профилактические меры против колоректального рака могут иметь место на разных уровнях. Определение возможных факторов риска и регулярное проведение рекомендуемых проверок – наиболее важные шаги в профилактике. Образ жизни может внести важный вклад в профилактику рака толстой кишки.
Неправильный образ жизни часто делает людей больными. Слишком мало упражнений, лишний вес, много жирной пищи, отсутствие фруктов и овощей, а также алкоголь – факторы риска.
По оценкам экспертов, уровень заболеваемости раком толстой кишки может быть уменьшен вдвое, если люди будут жить более здоровой жизнью
Первичная профилактика означает принятие мер против рака до того, как он начнется. Необходимо начать не только отказаться от вредных привычек, но и правильно питаться. Рекомендации просты в исполнении, экономически эффективны и осуществимы повсеместно.
Рекомендуется заниматься физической активностью 3 раза в неделю. Сбалансированная диета с большим количеством овощей, фруктов и клетчатки на 56% предотвращает раковые заболевания. Отказ от алкоголя, сигарет и нормализация веса помогают снизить риск развития воспаления кишечника.
Модифицированные бактерии-пробиотики помогают обнаружить раковые метастазы в печени.
Многие виды рака, включая рак поджелудочной железы и некоторые кишечные опухоли, при метастазировании особенно любят забираться в печень. Не надо объяснять, чем это грозит, но беды можно избежать, если вовремя обнаружить вторичный раковый очаг и избавиться от него. Печень хорошо регенерирует, и потому может легко перенести операцию и удаление больного кусочка ткани. Важно только обнаружить злокачественное образование как можно раньше – ведь чем раньше его из печени вырежут, тем лучше для больного.
Достаточно простой способ ранней диагностики рака – с помощью пробиотика и анализа мочи – описывают в своей статье в Science Translational Medicine сотрудники Массачусетского технологического института. Напомним, что пробиотиками называют микроорганизмы, используемые в терапевтических целях, например, для восстановления микрофлоры кишечника.
С другой стороны, довольно давно известно, что бактерии любят раковые опухоли: во-первых, там много питательных веществ, во-вторых, злокачественные клетки стараются обмануть, ослабить иммунитет там, где они живут, что опять же на руку микробам. Но для самой опухоли бактерии – совсем нежеланный гость, и ещё 200 лет назад врачи заметили, что инфекция может уменьшить раковую опухоль, а то и вовсе избавить больного от рака. Не так давно мы писали об экспериментах исследователей из Университета Джонса Хопкинса, которым удалось с помощь почвенной клостридии Clostridium novyi подавить развитие опухолей у нескольких онкобольных собак и одного человека.
В своей работе Сангита Бхатиа (Sangeeta Bhatia) и её коллеги использовали кишечную палочку с модифицированным геном lacZ. Фермент, кодируемый lacZ, расщепляет дисахарид лактозу на моносахара глюкозу и галактозу, но на сей раз он должен был расщеплять галактозу, соединённую с люминесцентным белком люциферином. Бактерии, расщепляя такую химерную молекулу, освобождали люциферин, который в скором времени оказывался в моче, где его легко можно было обнаружить с помощью фермента люциферазы: она окисляла люциферин с испусканием света.
Тест довольно простой: модифицированными бактериями в наши дни уже никого не удивить, а люциферазная реакция стала одной из самых распространённых лабораторных процедур, реагенты для неё дёшевы и доступны. Оставались два вопроса: как ввести бактерии в организм и как они будут себя в нём вести. Было решено, что бактериальный препарат должен быть таким, что его нужно будет просто глотать, как обычный пробиотик, для чего был выбран штамм кишечной палочки, который часто используют при проблемах с желудочно-кишечным трактом.
Эксперименты с мышами показали, что модифицированные кишечные палочки не обращали внимания не только на здоровые органы, но и на опухоли – если только они не были в печени. В неё они попадали, очевидно, прямо из пищеварительного тракта, через воротную вену. Это не значит, что бактерий больше нигде не было, просто печёночные опухоли они особенно любили, и здесь их оказывалось настолько много, что они могли произвести достаточное количество люминесцирующего белка, который выделялся с мочой. (Ещё раз подчеркнём, что в здоровой печени клетки кишечной палочки не скапливались.)
Бактерии и люциферазная реакция позволяют обнаружить злокачественные образования размером один кубический миллиметр, что делает такой метод самым чувствительным из существующих (ни компьютерная, ни магнитно-резонансная томография, если речь идёт о печени, настолько небольшие опухоли увидеть не могут). В самом ближайшем будущем полученные данные попробуют проверить в клинических испытаниях с онкобольными пациентами. Вместе с тем другие исследователей призывают авторов работы не останавливаться на достигнутом: так, Андреа Калифано (Andrea Califano) из Колумбийского университета предлагает внести в бактерии добавочные модификации, которые позволили бы им разрушать опухолевые клетки – чтобы кишечная палочка помогала не только обнаруживать рак, но и уничтожать его.
Кишечная палочка (Escherichia coli, E. coli) является палочковидной бактерией, принадлежащей к группе факультативных анаэробов (живет и размножается только в условиях отсутствия прямого кислорода).
Она имеет множество штаммов, большинство из которых принадлежит к естественной микрофлоре кишечника людей и помогает предотвращать развитие вредоносных микроорганизмов и синтезировать витамин К. Однако некоторые её разновидности (например, серотип О157:Н7) способны вызвать серьезные отравления, кишечный дисбактериоз и колибактериоз.
Нормальная микрофлора кишечника включает в себя множество микроорганизмов, среди которых – лактобактерии, энтерококки, стрептококки и проч. Штаммы этих бактерий находятся в равновесии, но если последнее каким-либо образом нарушится, патогенные микроорганизмы начнут усиленно размножаться. При этом активизируются процессы брожения и гниения, вызывая развитие серьезных заболеваний.
Некоторые штаммы кишечной палочки вызывают не только заболевания желудочно-кишечного тракта, но поражают также мочеполовую систему, провоцируют кольпит, цистит, простатит, менингит у младенцев, иногда становятся причиной развития гемолитически-уремического синдрома, перитонита, мастита, пневмонии и сепсиса.
Функции кишечной палочки в организме человека
Бактерии группы кишечной палочки необходимы для жизнедеятельности человека. В этой группе присутствуют различные микроорганизмы, которые называются колиформными бактериями.
Они составляют всего один процент от микрофлоры кишечника и решают ряд важных задач:
- выполняют защитную функцию, препятствуя развитию болезней;
- своим присутствием способствуют размножению бифидо- и лактобактерий;
- участвуют в обмене жиров и холестерина;
- участвуют в выработке витаминов В (всей группы) и K;
- улучшают всасывание соединений с железом и кальцием;
- укрепляют именную систему детей (до 7 лет).
Воздействие полезной кишечной палочки неоценимо в течение всей жизни, но патогенные штаммы этих бактерий провоцируют болезни, вызывают отравления, уничтожают полезную среду кишечника, деструктивно влияют на иммунитет взрослых и детей. В последнем случае это опасно вдвойне, поскольку неокрепший детский организм становится беззащитным к агрессивной внешней среде.
Кишечная палочка в норме
В нормальных условиях кишечная палочка заселяет кишечник человека (безопасные ее штаммы), среднее количество варьирует от 106 до 108 КОЕ/г содержимого дистального отдела кишечника (КОЕ – колониеобразующая единица). Содержание E.coli в составе другой микрофлоры кишечника не более 1%. В обычных условиях кишечная палочка принимают участие в нормальном функционировании кишечника, синтезирует витамины К, В1, В2, В3, В5, В6, В9, B12. Очень важная функция – конкурентное взаимодействие с условно-патогенной флорой кишечника (ограничение размножения условно-патогенных микроорганизмов).
Непатогенный штамм Nissle 1917 (Mutaflor) применяется с лечебной целью у детей в качестве пробиотика при дисбактериозе кишечника. В кишечнике более полезны так называемые лактозопозитивные кишечные палочки, содержание лактозонегативных не должно превышать 105 КОЕ/г, а гемолитические E. coli и вовсе должны отсутствовать.
Качественный и количественный состав E.coli толстого кишечника у здоровых людей разных возрастов, как у детей до года, так и старше 60 лет, не имеет различий. Для типичных E.coli это 107-108 КОЕ/г фекалий, E.coli лактозонегативные
Болею циститом 25 лет.В августе 2016 было резкое обострение с температурой 39 в течение 3 дней.Делали посев нашли кишеную палочку.Лечили гентамицином,нолицином,таваником,канефроном,фитолизином и закончила 2 месяца Уро=Ваксоном.Все это сопровождалось отваром урологический сбор.Сейчас сказали что вылечить невозможно.Неужели нет врачей и средств,которые могут вылечить?
Энтероинвазивная условно-патогенная бактерия, или кишечная палочка (Эшерихия коли – E. Coli), не является вирусом, как утверждают некоторые, она может стать причиной синдрома, похожего на шигеллезную инфекцию: обильный понос с наличием высокой температуры тела. Эти бактерии за счет использования определенного структурного белка (адгезина) взаимодействуют с клетками кишечника человека. Они продуцируют токсины в небольших количествах, но способны нанести повреждение стенке кишечника из-за клеточного разрушения. E. Coli имеет тесную связь с болезнетворной шигеллой, вызывающей инфекции шигеллез или дизентерию.
Краткая характеристика бактерий и вирусов
Бактерия имеет строение одноклеточного микроскопического организма, который наделен собственной энергетической системой. Все структурные элементы микробной клетки можно увидеть в обычный микроскоп. Она питается погибшими аминокислотами, витаминами и минеральными веществами, а не клетками человека. Образуя отходы собственной жизнедеятельности, засоряет и отравляет макроорганизм. Бактерии по своему строению классифицируются на палочки (к ним и относится эшерихия коли), кокки (в виде шаров) и спирохеты (имеют спиральный вид). В отличие от вирусов такая структура в микроскопической методике диагностирования подвергается определенному окрашиванию по Граму с использованием специальных красителей. В соответствии с этим они подразделяются на грамотрицательные (в поле зрения микроскопа красного цвета) и грамположительные (в микроскопе фиолетового цвета).
Вредная, безвредная эшерихия
Кишечная палочка выявлена в Германии бактериологом Теодором Эшерихом во второй половине 19 в., от имени ее открывателя получила название эшерихия коли.
Кишечная палочка – грамотрицательные бактерии, которые в нормальном состоянии обитают в нижнем отделе толстого кишечника. Большая часть эшерихий не болезнетворна, однако доля их (штамм O157) является причиной пищевого отравления у людей, а иногда вызывает порчу продукции. Непатогенные виды выступают как естественная микрофлора человеческого кишечника, их роль в организме:
- производство витамина K;
- недопущение размножения попавших в толщу кишечника болезнетворных микроорганизмов.
Такая нужная эшерихия
Кишечная палочка находится не всегда только в условиях кишечника. Она способна выжить в течение продолжительных сроков за пределами человеческого (или животного) тела, что делает ее идеальным показателем для анализа проб из окружающей среды на наличие фекалий.
Различные виды этих бактерий из-за внутриклеточного мутационного процесса часто принимают конкретные характеристики и свойства, что дает возможность выявить источник загрязнений в окружающей среде. К примеру, по штаммам, присутствующим в воде, можно предположить вероятный источник загрязнения: человек или животное (через биологические выделения – моча, испражнения).
Новые штаммы колипалочки возникают после естественной мутации, в результате которой ею приобретаются патогенные для человека свойства, вызывающие острую диарею и зачастую смертельный исход у детского организма в менее развитых государствах. Более вирулентные штаммы (O157) могут стать причиной серьезной патологии или летального исхода у пожилых людей, маленьких детей и людей со сниженным иммунным ответом.
Безобидная кишечная палочка проявляет опасность: причина в вирусе
Бактерии, продуцирующие токсин Шига, воздействуют на человеческий организм: возникает кровавый понос или недостаточность почек (об этом красноречиво говорит наличие микробов в моче по результатам анализа). Заболевание проявляется лишь под влиянием ряда причин, самая главная из которых – ген, что кодирует токсин Шига, последний не относится к врожденным, но есть в вирусе-бактериофаге. Иначе микроб должен быть заражен подобными вирусами еще до превращения в патогенный.
Микробиологическая характеристика эшерихии
Кишечные палочки являются грамотрицательными факультативными анаэробами, то есть такими микробами, которые способны расти и размножаться как в присутствии кислорода, так и без него. Микробная клетка имеет вид палочки размером примерно 2*0,5 мкм. Ее можно увидеть в обычный микроскоп, в отличие от вируса, который видимый исключительно в электронном.
Штаммы, имеющие жгутик, характеризуются способностью плавать, то есть двигаться. Кишечная палочка заселяет ЖКТ новорожденного на протяжении первых 40 часов жизни. Она попадает в организм человека вместе с пищевыми продуктами (молоком, детским питанием) или водой, а также от лиц, ухаживающих за новорожденным.
Кишечные инфекции
Инфицирование происходит через поедание немытых овощей или неправильно приготовленного (недостаточная термическая обработка) мяса. O157 является причиной гемолитическо-уремического синдрома. Указанный вид микроба был возбудителем в 2006 г. в США вспышки после употребления загрязненного этим микроорганизмом шпината. Тяжесть болезни варьирует: от незначительных симптомов в виде нечастого жидкого стула до смерти у детей младшего возраста, пожилых или с ослабленным иммунитетом. Однако основную часть инфекционных процессов, вызванных этой бактерией, занимают нетяжелые формы. Неудовлетворительные санитарно-гигиенические условия приготовления блюд из мяса в 1996 году в Шотландии привели к смертельному исходу семерых и сотне зараженных.
Некоторые кишечные палочки (O157, O121, O104) способны продуцировать энтеротоксин, по своему строению и функциям близкий к холерному, то есть он вступает во взаимодействие с клеткой кишечной стенки и не допускает поглощение жидкости, приводя таким образом к диарее.
В случае попадания этого микроба из кишечника в межкишечное пространство через естественную (язвенная эрозия) или искусственную (хирургический генез или травма) перфорацию он становится причиной перитонита.
Колибактерия достаточно чувствительна к стрептомицину или гентамицину. Однако такое свойство может исчезнуть, так как эшерихия быстро становится резистентной к лекарственным препаратам.
Эпидемиология и профилактика инфекции ЖКТ
Передача вирулентного микроба происходит посредством фекально-орального механизма. Полив сельхозкультур зараженными этим микробом водами (а также сточными), а вследствие этого крупы или овощи, соки, необработанные молочные и другие продукты питания, а вдобавок к этому и заболевшие (носители) работники пищевой промышленности могут стать факторами распространения кишечной инфекции, вызванной эшерихией. Источником инфекции может быть больной или носитель. Источники имеют также разный путь выделения из организма человека:
- через выделения из ЖКТ (испражнения);
- через мочу (при попадании микроорганизмов в мочеполовую систему и хронизации процесса).
Фекально-оральный механизм распространения инфекционного процесса прерывается правильным приготовлением пищевых продуктов (соблюдение условий и требований термообработки), предотвращением вторичного загрязнения, санпросветработами среди населения и работников пищевой промышленности и общественного питания.
Инфекции мочевыводящих путей
Уропатогенная кишечная палочка выступает возбудителем около 90% инфекционных патологий в мочевыводящих путях. В процессе восхождения фекальные микробы (в моче) заселяют уретру и поднимаются до мочевого пузыря и почек, или в мужском организме до предстательной железы. Так как женщины имеют значительно короткий мочеиспускательный канал (в сравнении с мужчинам), примерно в 14 раз чаще подвергаются инфицированию бактериями Е Coli.
В некоторых случаях уропатогенные инфекции способны уходить от иммунной реакции организма в виде образования так называемых биопленок, которые, в свою очередь, также резистентны к антибиотиковому лечению, что приводит зачастую к хронизации процесса (это проявляется в периодическом выявлении описанных микробов в моче в результате бактериологического тестирования).
Нисходящий путь инфицирования фекальными микробами происходит за счет попадания в мочеполовую систему посредством крови, то есть при наличии бактериемии. В этом случае обязательно будут присутствовать кишечные палочки в моче по результатам анализа.
Диагностика заболеваний
Обычно диагностирование осуществляется с помощью микробиологического исследования (выращивания бактерий на определенных питательных средах) и серологических реакций (анализа крови). Для диагностики используются биоматериал от больного (испражнения и моча).
Дополнительно используют методы для обнаружения патогенной кишечной палочки в виде ИФА в электронном микроскопе, прямой микроскопии (обычный микроскоп). Такие тесты используются как скрининг-анализ для оперативного определения болезнетворной кишечной палочки в моче, испражнениях, крови без дополнительного выращивания микробов.
Лечение
Противобактериальная терапия подразумевает лечение антибиотиками. Чувствительность к ним разных штаммов эшерихии различается. С целью лечения инфекций, возбудители которых – кишечная палочка, назначают амоксициллин и другие полусинтетические пенициллины цефалоспоринового ряда, аминогликозидов и другие. Однако нельзя назначать антибиотики для самолечения подобных инфекций, поскольку часть последних может вызвать и побочную реакцию, проявляющуюся аллергией, или осложнения в виде нарушения со стороны почек, зрения и т.д.
Существует особенный метод лечения такой инфекции. Это терапия вирусом-бактериофагом. Она получила наибольшее развитие в последние 80 лет, в основной части на территории бывшего СССР. В современной медицине остались центры подобной методики только в Грузии и в Польше. Бактериофаг Т4 – достаточно изученный вирус, применяется для лечения инфекций, вызванных колибактериями.
Образование высшее филологическое. В копирайтинге с 2012 г., также занимаюсь редактированием/размещением статей. Увлечения — психология и кулинария.
Кишечная палочка считается одним из самых распространенных бактерий. Область ее обитания – кишечник человека и некоторых животных. Считается, что после попадания в окружающую среду (бактерия выводится из организма вместе с каловыми массами), она может в течение длительного периода сохранять свою жизнеспособность даже под воздействием внешних факторов.
Бактерии рода кишечной палочки могут быть как безопасными для организма человека, так и патогенными, способными привести к развитию многочисленных заболеваний. Для этих патологий характерны свои ярко выраженные симптомы. При их появлении человеку необходимо срочно обратиться в медицинское учреждение, иначе недуг, вызванный возбудителем, может привести к развитию серьезных осложнений, жизненно-опасных для человека.
Характеристика микроорганизма
Кишечная палочка представляет собой бактерию рода Escherichia из семейства Enterobacteriaceae. Данный микроорганизм активно размножается в человеческом организме, в частности, в различных отделах кишечника. Попадая вместе с каловыми массами в окружающую среду, бактерия может на протяжении нескольких месяцев сохранять свою жизнеспособность. Активная микрофлора содержится в воде, почве, кале, а также в некоторых продуктах питания (особенно, в молоке, мясе).
Кишечную палочку принято разделять на непатогенную и патогенную. Представители нормальном микрофлоры, обитающие в кишечнике, оказывают ряд полезных для организма действий. Прежде всего, данные микроорганизмы нормализуют кишечную микрофлору, подавляя рост вредных бактерий. Кроме того, они синтезируют витамин К, необходимый для поддержания нормального процесса свертываемости крови и выполнения других важных функций в организме.

Некоторые из представителей данного вида способны выделять ферменты, расщепляющие лактозу. Однако, безопасными данные бактерии остаются лишь тогда, когда они находятся в полости кишечника. При проникновении в другие органы, непатогенная микрофлора может спровоцировать развитие воспаления.
Классификация и виды бактерий
Бактерии группы кишечной палочки могут быть безопасными и патогенными. В свою очередь, непатогенная микрофлора может быть лактозопозитивными (в большинстве случаев), то есть способными расщеплять лактозу, либо лактозонегативными, не имеющими такой способности.
Патогенные микроорганизмы принято разделять на следующие виды:
- Энтерогеморрагическая кишечная палочка – группа бактерий, приводящая к развитию диареи и кишечных кровотечений;
- Энтеропатогенная – бактерии данного вида негативно воздействуют на эпителиальный слой кишечника, разрушая его ворсинки. Результатом такого воздействия становится продолжительное нарушение стула и метаболических процессов;
- Энтероинвазивная – микроорганизмы внедряются в ткани кишечных стенок, что приводит к развитию выраженного очага воспаления.

Причины и пути передачи
Необходимо понимать, какие причины способствуют проникновению патогенной кишечной палочки в организм и ее активизации (размножению) в кишечнике. К числу таких причин относят:
- Нарушение микрофлоры кишечника, в частности, массовая гибель полезных микроорганизмов в результате заболеваний ЖКТ;
- Патологии поджелудочной железы;
- Воспаления в кишечнике;
- Длительное употребление антибактериальных препаратов (несмотря на то, что данная лекарственная группа предназначена именно для борьбы с патогенной микрофлорой, бесконтрольный прием антибиотиков может привести к обратной ситуации: бактерии приспосабливаются к действию лекарства и теряют чувствительность к его активным веществам. В результате этого происходит усиленный рост численности вредной микрофлоры);
- Несоблюдение правил личной гигиены;
- Употребление зараженных продуктов питания и воды.
Кишечная палочка, относящаяся к патогенному виду, попадает в организм человека различными способами:
- Через продукты питания. Например, если человек употребляет сырое молоко, мясо, не прошедшее должную термическую обработку, сырое молоко;
- Контактно – бытовой способ, например, при контакте с больным человеком (через немытые руки), при использовании зараженных вещей и предметов обихода;
- Родовой способ, когда бактерия передается новорожденному от больной матери;
- Половой. Во время полового акта кишечная палочка также может проникнуть в организм, хотя происходит это довольно редко.
Характерные симптомы
При активном развитии патогенной кишечной палочки в организме человека, появляются специфические симптомы, такие как потеря аппетита, диарея, тошнота и рвота, болезненные ощущения в различных отделах живота. При этом меняется структура, цвет и запах каловых масс. Кал становится более жидким, водянистым, может приобретать слизистую консистенцию. Цвет его становится более светлым, возможно появление в каловых массах кровянистых прожилок. Кал приобретает более резкий и неприятный запах.
У больного наблюдается обильное отхождение рвотных масс. При этом рвота приобретает специфический зеленый оттенок и резкий запах. У пациента отмечается выраженная слабость, отсутствие работоспособности, головокружения. В тяжелых случаях развивается нарушение жидкостного баланса организма со всеми характерными для данного состояния симптомами (бледность, сухость эпидермиса и наружных слизистых оболочек, слабость, постоянная жажда).
Стадии и проявления
Клинические признаки развития опасных заболеваний, возбудителем которых является кишечная палочка патогенного типа, зависят от давности проникновения болезнетворной микрофлоры в кишечник, а также от количества бактерий и продуктов жизнедеятельности, выделяемых ими. В соответствии с этими параметрами, выделяют 3 стадии развития патологического процесса. Для каждой из них характерен свой набор признаков.
| Этап | Проявления и симптомы |
| Начальная стадия патологии, когда в организме человека наблюдается незначительное количество патогенной микрофлоры. | Симптомы и проявления патологического процесса носят умеренный характер. Больного беспокоит периодически появляющаяся слабость, умеренная диарея (или запор), чувство распирания в животе, возникающее через некоторое время после приема пищи. |
| Этап развития, во время которого увеличивается рост численности патогенных микроорганизмов, полезные бактерии, напротив, начинают отмирать. | Возникает выраженное расстройство желудка, сопровождающееся обильным выделением каловых масс, которые теперь имеют водянистую или слизистую консистенцию. Во время акта дефекации пациент испытывает тянущую боль внизу живота. Усиливается рвота. Пациент теряет аппетит, его самочувствие ухудшается в значительной степени. Имеет место повышение температуры, озноб. |
| Завершающая стадия. | На данном этапе симптомы имеют наиболее выраженную характеристику. В тяжелых случаях развивается кровавая диарея, обезвоживание, рвотные массы приобретают зеленый цвет. В этом случае пациенту необходима экстренная госпитализация. |
При нормальном течении патологического процесса происходит постепенное самоочищение кишечника, после чего наступает улучшение.
Осложнения и заболевания
Патогенная форма кишечной палочки может приводить к развитию весьма неприятных последствий, заболеваний, значительно нарушающих самочувствие человека, несущих реальную угрозу для его здоровья. У женщин кишечная палочка, проникающая в область уретры или влагалища, может привести к таким патологиям как кольпит, уретрит. Частыми заболеваниями, возникающими у представительниц прекрасного пола, являются цистит, эндометрит, пиелонефрит, аднексит. Также возникают различные неприятные симптомы, такие как сильный и болезненный зуд во влагалище, творожистые, резко пахнущие выделения из половых органов.
У мужчин развиваются такие патологии как обильная диарея, токсическое поражение организма, сопровождающееся рвотой, ухудшением общего состояния. Возможно развитие следующих заболеваний: простатит, орхит, эпидидимит, пиелонефрит, воспаление тканей мочевого пузыря и нарушение его функциональности (анурия, энурез).
Особенно опасной патогенная кишечная палочка считается для детей. У зараженного ребенка наблюдается значительная гипертермия, сильный и зловонный понос, потеря аппетита и массы тела, признаки обезвоживания, истощения. Нарушается работа иммунной системы. Появляются области нагноения, которые могут привести к токсическому заражению крови и внутренних органов.
Методы диагностики
Для того, чтобы назначить подходящее лечение, необходимо поставить точный диагноз. Для этого используют различные диагностические мероприятия. Прежде всего, врач проводит беседу с пациентом, устанавливает совокупность симптомов и жалоб, беспокоящих больного, длительность и обстоятельства их появления. После этого больному назначают различные лабораторные и инструментальные обследования.
Инструментальные способы диагностики необходимы для того, чтобы выявить поражения кишечника и других органов (почки, желчный пузырь). Использование таких методов необходимо не всегда, а только в том случае, если имеются симптомы соответствующих заболеваний.
Для выявления патологического процесса большое значение имеют именно лабораторные методы исследования, позволяющие не только выявить нарушения микрофлоры, но и определить конкретного возбудителя инфекции, оценить степень его чувствительности к тем или иным антибактериальным веществам. Это необходимо для выбора подходящей схемы лечения.
- Анализ крови на кишечную палочку. В норме данный микроорганизм в крови не содержится. Если же бактерию обнаруживают, это говорит о том, что здоровье и жизнь человека находятся в опасности, ведь проникновение возбудителя в кровоток может спровоцировать развитие сепсиса (заражения крови) – жизненно-опасного состояния, способного привести к летальному исходу.
- Исследование мочи. Обнаружение возбудителя в моче говорит о заражении органов мочевыделительной системы и необходимости срочной антибактериальной терапии. О стадии развития заражения судят по количеству бактерий, имеющимся признакам;
- Мазок из влагалища. В норме кишечная палочка в мазке отсутствует. Если же она обнаружена, это свидетельствует о заражении органов репродуктивной системы;
- Исследование кала. При развитии кишечной палочки данные микроорганизмы в большом количестве присутствуют в каловых массах (в норме содержание этих микроорганизмов допускается, но в значительно меньшем количестве). После того, как возбудитель обнаружен, выполняется процедура бактериального посева. То есть бактерию помещают в особую среду, после чего оценивают дальнейшее ее развитие и размножение. Это позволяет определить тип микроорганизма, его чувствительность к различным видам антибиотиков.
Методы терапии
Лечение патологий, вызванных кишечной палочкой, включает в себя следующие моменты:
- Медикаментозная терапия и прием витаминов для восстановления иммунитета;
- Использование средств – пробиотиков для нормализации кишечной микрофлоры и устранения дисбактериоза;
- Соблюдение особого режима питания.
Медикаментозное лечение предполагает использование лекарственных средств различных групп. Это, прежде всего антибиотики, препараты для устранения воспалений в мочевыводящих органах, органах половой системы, средства, предотвращающие развитие обезвоживания, препараты, восстанавливающие здоровую микрофлору в кишечнике, витаминные препараты для укрепления иммунной системы.
Диета предполагает употребление большого количества кисломолочных продуктов, обогащенных полезными бактериями, овощей и фруктов, нормализующих процесс пищеварения, травяных отваров, обладающих противовоспалительным действием. Запрещено употребление блюд, тяжелых для переваривания и продвижения по пищеварительному тракту. Это жирные и жареные блюда, острые, соленые, сладкие продукты, газированная вода, полуфабрикаты, консервы и колбасные изделия, а также же продукты, вызывающие чувство дискомфорта у конкретного человека.
Читайте также: